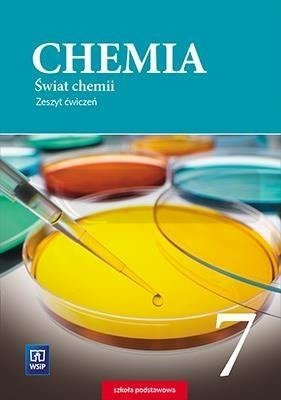

Rodzaje i przemiany materii
Budowa materii
Wiązania i reakcje chemiczne
Gazy
Woda i roztwory wodne
Zamieszczone w zeszycie ćwiczenia i zadania mają zróżnicowany stopnień trudności i umożliwiają pracę z uczniami na różnych poziomach. Porządkują i utrwalają zdobyte na lekcji wiadomości i umiejętności. Część zadań została zgrupowana w bloki Chemiczne rachunki pozwalają one trenować wykonywanie obliczeń chemicznych.
Każdy dział rozpoczyna się tabelą umiejętności, która ma pomóc uczniowi w planowaniu pracy oraz w dokonaniu samooceny. Zawiera ona wykaz wymagań edukacyjnych, sformułowanych zgodnie z podstawą programową.
Na końcu każdego działu znajdują się zadania podsumowujące, które warto rozwiązać przed lekcją powtórzeniową. Wśród nich mapy myśli, których rysowanie sprzyja lepszemu zrozumieniu i zapamiętaniu nowych treści.
Powtórzenie wiadomości i umiejętności znajdujące się na końcu zeszytu zawiera zadania i mapy myśli dotyczące wszystkich zagadnień omawianych w klasie 7.
Marka
Symbol
9788302168772
Autor
Dorota Lewandowska, Anna Warchoł
Wydawnictwo
WSiP
Ilość stron
120
Format
17x24 cm
Oprawa
broszurowa
Klasa
SP 7
Przedmiot
Chemia
ISBN
9788302168772
Napisz swoją opinię
Zapytaj o produkt